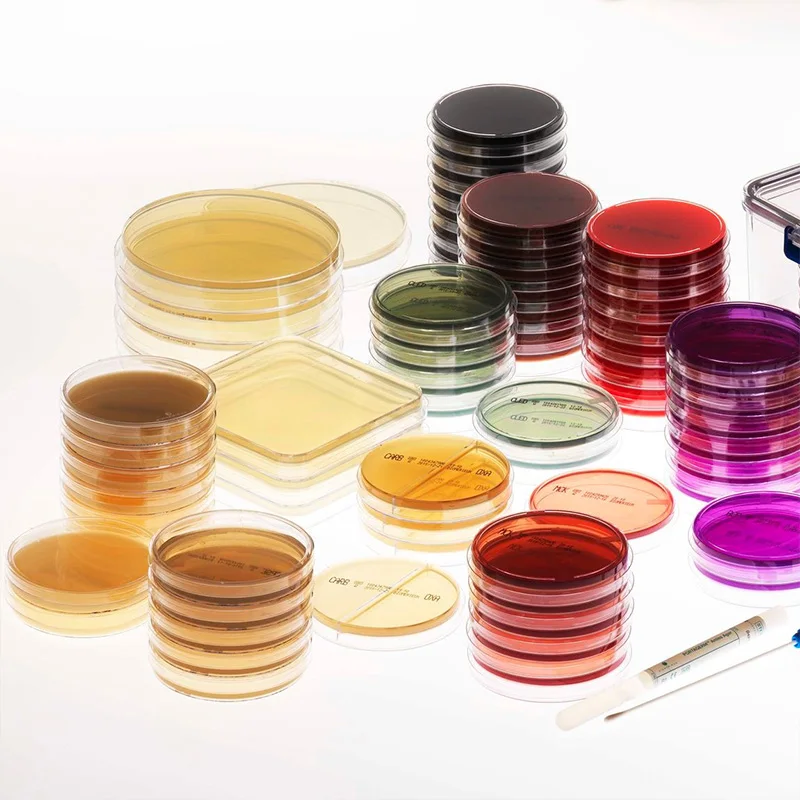

Химические медицинские лабораторные реагенты средний DMEM для культивирования
- Категория: Lab Supplies >>>
- Поставщик: Huachenyang,(shenzhen),Technology,Co.,Ltd.
Поделиться:
Описание и отзывы
Трекер стоимости
| Месяц | Минимальная цена | Макс. стоимость |
|---|---|---|
| Sep-16-2025 | 0.43 $* | 0.86 $* |
| Aug-16-2025 | 0.53 $* | 0.70 $* |
| Jul-16-2025 | 0.86 $* | 0.99 $* |
| Jun-16-2025 | 0.19 $* | 0.46 $* |
| May-16-2025 | 0.29 $* | 0.27 $* |
| Apr-16-2025 | 0.96 $* | 0.2 $* |
| Mar-16-2025 | 0.65 $* | 0.10 $* |
| Feb-16-2025 | 0.90 $* | 0.12 $* |
| Jan-16-2025 | 0.65 $* | 0.71 $* |
Характеристики
Recommend Products
Company Profile
Huachenyang (Shenzhen) Tech Co., Ltd., as China leading manufacturer on medical disposable, Rapid CE-IVD Test kit &lab reagents,&Stem cells projects.With two GMP factory as class 100,000 clean room, class 10,000 lab, class 100 production unit and more than 29 registered patents,research cooperation with domestic universities & top class biomedical lab, we’re gradually certified by CE TGA NMPA ISO13485 MEDL and our swab published on "Nature" 3 times in the past 3 years.. Our global well known brand iclean products including the swab, VTM kit, nucleic acid extraction kit, rapid test kit,are sold to more than 129 countries,Cooperated with WHO, NHS &Mayo clinic,MGI,DDC,Yale University,Cleveland clinic etc.
Product Description
Cell Culture Media for Laboratory Research
Cell culture media generally comprise an appropriate source of energy and compounds which regulate the cell cycle. A typical culture medium is composed of a complement of amino acids, vitamins, inorganic salts, glucose, and serum as a source of growth factors, hormones, and attachment factors.







FAQ
Q1.Does your company require employees to work overtime?
A:Our company does not allow employees to work overtime, strictly in accordance with the management system!
Q2: Do you support OEM/ODM?
A: YES, we can prototype and customize the ideal product according to your specific application.
Q3: Do you have GMP Lab?
A: YES, we have our GMP Lab built in 2016.
Q4: Do you have any certificates?
A: YES, we have all the certificates required for export and local import custom clearance.
Q5: How long have you been in manufacturing medical consumables?
A: Established on 2008, our factory offer production, sales,delivery one-stop service.
Q6: What's your lead time?
A: For mass production, we deliver by batches and first batch can be delivered within 5 days.
Q7: Do you have any certificates?
A: YES, we have all the certificates (ISO13485,CE,FSC,TGA,NMPA)required for export and local import custom clearance.
Disposable applicators transport collection swabs oral swab
Disposable applicators transport collection swabs oral swab
Disposable applicators transport collection swabs oral swab
Похожие товары
504201, 96 лунцевых пластин ELISA с высокой связью
US $1.00-$1.50
Портативный термофлюорометр
US $4200-$4600